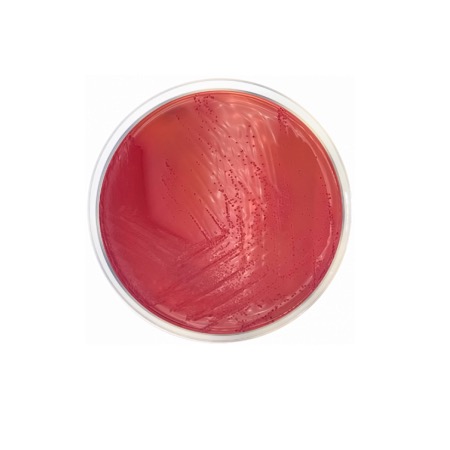
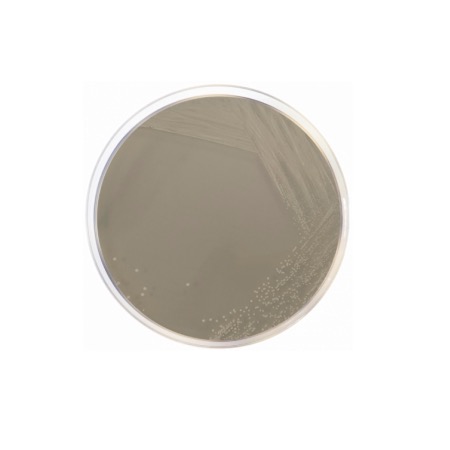
product
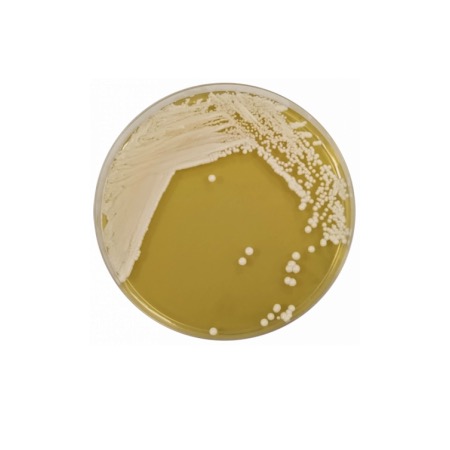
product

The medium’s high selectivity and characteristic colonial appearance are due to the CIN (Cefsulodin, Irgasan, Novobiocin) formulation. The Peptone Mixture and Yeast Extract provide nitrogen, vitamins, and minerals. Selectivity is achieved through the combination of Irgasan (Triclosan), which inhibits most Gram-positive and Gram-negative bacteria, and Sodium Desoxycholate and Crystal Violet, which suppress the growth of Enterobacteriaceae and other Gram-positives. Mannitol is the fermentable carbohydrate; Yersinia enterocolitica ferments mannitol, producing acid that causes the Neutral Red indicator to turn red. When the selective supplement (Cefsulodin and Novobiocin) is added, the growth of competing flora is further restricted, allowing Yersinia to develop its characteristic "bull's-eye" colony morphology (a deep red center with a transparent border).
Advantages
- ISO 10273 Compliance: Formulated specifically to meet the international standard for the horizontal method of Yersinia enterocolitica detection.
- Distinctive Morphology: The "bull's-eye" appearance of the colonies allows for rapid and easy presumptive identification among background flora.
- High Selectivity: The potent combination of Irgasan, Cefsulodin, and Novobiocin effectively suppresses Pseudomonas, Proteus, and other enteric contaminants.
- Optimized Recovery: Specifically designed to recover Yersinia after cold enrichment or selective enrichment steps.
- Reliable Quality Control: A standard medium in clinical microbiology for the diagnosis of gastroenteritis caused by Yersinia species.
Technical specifications
| Catalogue number |
1126 |
| Brand |
Condalab |
| Application |
Isolation of Yersinia enterocolitica according to ISO 10273 |
| Typical Composition (g/L) |
Peptone Mixture (20.0); Yeast Extract (2.0); Mannitol (20.0); Sodium Chloride (1.0); Sodium Desoxycholate (0.5); Sodium Pyruvate (2.0); Magnesium Sulfate (0.01); Irgasan (0.004); Neutral Red (0.03); Crystal Violet (0.001); Bacteriological Agar (14.0) |
| Final pH (at 25 °C) |
7.4 ± 0.2 |
| Preparation |
59.5 g/L (plus Supplement) |
| Storage Temperature |
2 – 25 °C |
Available packaging options
| 1126 |
500 g plastic bottle |